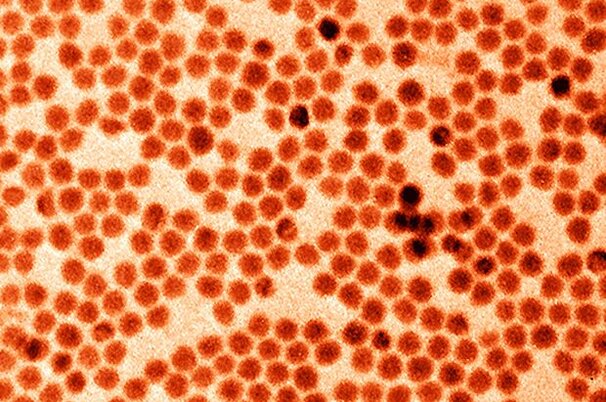
39696_8.jpg

Artikel werden durchsucht.
Pflanzen
Spezialkulturen
Oliven im Klimawandel: Gewinner- und Verliererregionen
Tiere
Milchvieh
Elektrosmog beeinflusst Kühe
Pflanzen
Forschung
Eisendüngung kühlte Eiszeitklima
Tiere
Übrige Tiere
Kuckucke schützen Gastgeber vor Räubern
Landtechnik
Neuheiten
Nanokristalle für stärkere Batterien entwickelt
Politik & Wirtschaft
Agrarwirtschaft
Was tun, wenn der Strom ausfällt
Pflanzen
Ackerbau
Mit Apps erfolgreicher ackern
Vermischtes
Bauernkalender
Bauernkalender 2014: Damian gefiel es auf der Alp am besten
Vermischtes
Allerlei
Argentinien war beliebtes Ziel von Schweizer Emigranten
Politik & Wirtschaft
Agrarpolitik
Wird jetzt mehr Bauland rückgezont?
Das Wetter heute in
Lesershop
Umfrage

Sollen alle Nutztiere gesetzlichen Anspruch auf Auslauf im Freien haben?
- Ja, wenn betrieblich möglich:41.32%
- Nein:57.37%
- Bin mir noch unsicher:0.72%
- Halte keine Nutztiere:0.6%
Teilnehmer insgesamt: 1670
Bekanntschaften
Suchen Sie Kollegen und Kolleginnen für Freizeit und Hobbies? Oder eine Lebenspartnerin oder einen Lebenspartner?